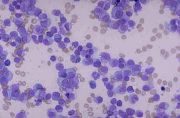

由Admin上传
来自医学百科
本特殊页面展示所有上传的文件。
| 日期 | 名称 | 缩略图 | 尺寸 | 说明 | 版本 |
|---|---|---|---|---|---|
| 2014年1月19日 (日) 00:45 | Bk0tx.jpg (文件) |  |
21 KB | 1 | |
| 2014年1月19日 (日) 00:44 | Gkpdtqgn.jpg (文件) |  |
20 KB | 1 | |
| 2014年1月19日 (日) 00:44 | Bkati.jpg (文件) | |
11 KB | 1 | |
| 2014年1月19日 (日) 00:44 | Gunvl02j.jpg (文件) |  |
28 KB | 1 | |
| 2014年1月19日 (日) 00:44 | Bkewq.jpg (文件) |  |
61 KB | 1 | |
| 2014年1月19日 (日) 00:44 | Bke3w.jpg (文件) |  |
6 KB | 1 | |
| 2014年1月19日 (日) 00:44 | Glanhnsh.jpg (文件) |  |
17 KB | 1 | |
| 2014年1月19日 (日) 00:44 | Bk8i1.jpg (文件) |  |
13 KB | 1 | |
| 2014年1月19日 (日) 00:44 | Glmgidey.jpg (文件) |  |
59 KB | 1 | |
| 2014年1月19日 (日) 00:44 | Bkjhw.jpg (文件) |  |
34 KB | 1 | |
| 2014年1月19日 (日) 00:44 | Bkq33.jpg (文件) |  |
112 KB | 1 | |
| 2014年1月19日 (日) 00:44 | Gj5rvpv8.jpg (文件) |  |
25 KB | 1 | |
| 2014年1月19日 (日) 00:44 | Bk0zb.jpg (文件) |  |
6 KB | 1 | |
| 2014年1月19日 (日) 00:44 | Bkhf8.jpg (文件) |  |
48 KB | 1 | |
| 2014年1月19日 (日) 00:43 | Bk24y.jpg (文件) |  |
29 KB | 1 | |
| 2014年1月19日 (日) 00:43 | Glxq0vjj.jpg (文件) |  |
42 KB | 1 | |
| 2014年1月19日 (日) 00:43 | Bkklv.jpg (文件) |  |
26 KB | 1 | |
| 2014年1月19日 (日) 00:43 | Bkjsz.jpg (文件) |  |
161 KB | 1 | |
| 2014年1月19日 (日) 00:43 | Gra6kfpl.jpg (文件) | 5 KB | 1 | ||
| 2014年1月19日 (日) 00:43 | Bk5h6.jpg (文件) |  |
2 KB | 1 | |
| 2014年1月19日 (日) 00:43 | Gv12bbfm.jpg (文件) |  |
23 KB | 1 | |
| 2014年1月19日 (日) 00:43 | Bkj2s.jpg (文件) |  |
8 KB | 1 | |
| 2014年1月19日 (日) 00:43 | Bka3c.jpg (文件) |  |
11 KB | 1 | |
| 2014年1月19日 (日) 00:43 | Gmob9x3z.jpg (文件) | 9 KB | 1 | ||
| 2014年1月19日 (日) 00:43 | Bkl1g.jpg (文件) |  |
5 KB | 1 | |
| 2014年1月19日 (日) 00:43 | Vita.jpg (文件) |  |
8 KB | 1 | |
| 2014年1月19日 (日) 00:43 | Bkofx.jpg (文件) |  |
417 KB | 1 | |
| 2014年1月19日 (日) 00:43 | Bk9mq.jpg (文件) |  |
18 KB | 1 | |
| 2014年1月19日 (日) 00:42 | Gktkgxov.jpg (文件) |  |
9 KB | 1 | |
| 2014年1月19日 (日) 00:42 | Bkqqv.jpg (文件) |  |
55 KB | 1 | |
| 2014年1月19日 (日) 00:42 | Gus5jtic.gif (文件) |  |
2 KB | 1 | |
| 2014年1月19日 (日) 00:42 | Bkp3v.jpg (文件) |  |
75 KB | 1 | |
| 2014年1月19日 (日) 00:42 | Bk1xd.jpg (文件) |  |
106 KB | 1 | |
| 2014年1月19日 (日) 00:42 | Gra7a7f2.jpg (文件) |  |
35 KB | 1 | |
| 2014年1月19日 (日) 00:42 | Bkcfa.jpg (文件) |  |
106 KB | 1 | |
| 2014年1月19日 (日) 00:42 | Bk483.jpg (文件) |  |
3 KB | 1 | |
| 2014年1月19日 (日) 00:42 | Bkqgp.jpg (文件) |  |
50 KB | 1 | |
| 2014年1月19日 (日) 00:42 | Bk5qu.jpg (文件) |  |
26 KB | 1 | |
| 2014年1月19日 (日) 00:42 | Bkpm2.jpg (文件) |  |
57 KB | 1 | |
| 2014年1月19日 (日) 00:42 | Gmoq5ewp.jpg (文件) |  |
8 KB | 1 | |
| 2014年1月19日 (日) 00:42 | Bkak6.jpg (文件) |  |
39 KB | 1 | |
| 2014年1月19日 (日) 00:41 | Bk3hy.jpg (文件) |  |
15 KB | 1 | |
| 2014年1月19日 (日) 00:41 | Bkd43.jpg (文件) |  |
14 KB | 1 | |
| 2014年1月19日 (日) 00:41 | Bk024.jpg (文件) |  |
14 KB | 1 | |
| 2014年1月19日 (日) 00:41 | Bk3i2.jpg (文件) |  |
267 KB | 1 | |
| 2014年1月19日 (日) 00:41 | Go72880d.gif (文件) |  |
3 KB | 1 | |
| 2014年1月19日 (日) 00:41 | Bkjzo.jpg (文件) |  |
4 KB | 1 | |
| 2014年1月19日 (日) 00:41 | Go84s14m.gif (文件) |  |
9 KB | 1 | |
| 2014年1月19日 (日) 00:41 | Bkl45.jpg (文件) |  |
2 KB | 1 | |
| 2014年1月19日 (日) 00:41 | Bk3sa.jpg (文件) |  |
5 KB | 1 |